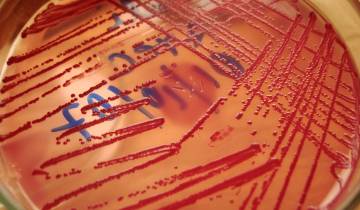

Cet article décrit l'origine de l'ulcère gastro-duodénal, le traitement actuel et les perspectives dans le cadre de la santé publique.
Historique
L’ulcère gastrique, également appelé ulcère de l’estomac, et l’ulcère duodénal sont des pathologies qui correspondent au développement d’une plaie au niveau de la muqueuse de l’estomac ou du duodénum. On regroupe souvent ces deux pathologies sous le terme d’ulcère gastroduodénal de par leurs similitudes.
L’histoire de l’évolution des connaissances sur ces deux pathologies et de leurs traitements associés est intéressante. En effet, le stress a longtemps été considéré comme la cause principale de ces deux maladies. Les guérisons étaient donc rares et la maladie le plus souvent chronique, touchant environ 10 % de la population. Mais cette situation a été radicalement modifiée au début des années 1980 par Barry J. Marshall et J. Robin Warren, deux chercheurs australiens. En effet, leurs travaux ont démontré que la majorité des ulcères gastroduodénaux sont dus à la présence d’une bactérie qu’ils ont découverte et isolée : Helicobacter pylori. Cette idée a fini par s’imposer, non sans résistance, et les traitements proposés de nos jours sont basés sur une antibiothérapie. En soignant la cause, ils permettent non seulement de diminuer les symptômes mais surtout d’obtenir fréquemment une guérison. Pour cette découverte et ces applications, Marshall et Warren ont reçu de nombreux prix et distinctions, dont le prix Nobel 2005 de physiologie ou médecine.
Observation en microscopie électronique à balayage.
Étiologie de l’ulcère gastroduodénal
Un ulcère est une plaie ouverte, c’est-à-dire une perte macroscopique de substance d’un épithélium cutané ou d’une muqueuse, et qui a pour particularité d'avoir tendance à ne pas cicatriser spontanément. L’ulcère gastrique est une plaie située au niveau de la muqueuse de l’estomac tandis que l’ulcère duodénal touche le duodénum, la première partie de l’intestin grêle qui fait suite à l’estomac. Sans traitement, la cicatrisation n’étant pas spontanée, la maladie est chronique.
L’apparition d’un ulcère gastroduodénal est due à un déséquilibre entre les facteurs d’agression auxquelles sont soumises ces muqueuses et leurs mécanismes de défense. En effet, l’environnement gastrique et duodénal est agressif : pH acide et présence d’enzymes digestives. Les cellules muqueuses sont protégées par un mucus et rapidement renouvelées.
Le déséquilibre peut donc provenir soit d’une augmentation des facteurs d’agression (hypersécrétion d'acide gastrique, reflux gastro-duodénal, etc.) ou d’une diminution des défenses (anomalie du mucus, diminution du flux sanguin de la muqueuse, etc.). Il peut y avoir plusieurs causes à l’apparition de ce déséquilibre. On peut citer la prise d’anti-inflammatoires non stéroïdiens comme l’ibuprofène ou l’aspirine qui entraînent la diminution de la production de prostaglandines, favorisant l’augmentation de l’acidité gastrique et la diminution du mucus (voir l’article « L’aspirine »), mais aussi le tabac.
Longtemps, on y a vu l’expression du stress. Or, il est maintenant prouvé que la bactérie Helicobacter pylori est le principal agent responsable des ulcères gastroduodénaux. Cette bactérie est ainsi retrouvée chez 90 % environ des personnes ayant un ulcère duodénal et 80 % environ de celles présentant un ulcère gastrique.
Helicobacter pylori secrète différentes substances dont des enzymes, qui vont modifier le mucus protecteur des cellules, ainsi que des molécules entraînant une réaction inflammatoire locale. Elle augmente également la sécrétion acide, ce qui abaisse le pH. Tout ceci engendre une libération d’enzymes lysosomiales et de radicaux libres par les cellules, provoquant des lésions cellulaires et enfin un ulcère.
Il faut signaler que, sans que l’on sache bien l’expliquer, le développement d’un ulcère n’est pas automatique en présence de la bactérie. En moyenne, 50 % des humains hébergent Helicobacter pylori (30-40 % en France, jusqu’à 80 % dans certains pays) mais seuls 10 % développent un ulcère gastroduodénal en France (dans 80 % des cas il s’agit d’un ulcère duodénal).
Pour les malades, la guérison passe par l’élimination de la bactérie. Le traitement classique associe la prise de deux antibiotiques différents, couplée à un traitement anti-acide. On utilise deux antibiotiques pour limiter les risques de résistance, mais aussi du fait que la bactérie est difficile à atteindre (elle est cachée au fond des cryptes de la muqueuse stomacale ou duodénale). Le taux de guérison est élevé, de l’ordre de 90 %, et durable. En effet, il est très rare que l’infection à Helicobacter pylori ait lieu à l’âge adulte. La plupart du temps, la contamination est réalisée entre 0 et 5 ans (transmission mère-enfant prépondérante). Une fois la bactérie éliminée, il est donc rare que la personne soit de nouveau infectée.
Perspectives
Dans les années 1980, l’idée que Helicobacter pylori puisse être la cause principale des ulcères gastroduodénaux s’est imposée difficilement. Elle est maintenant bien établie et a bouleversé le traitement proposé aux personnes atteintes. Mais au-delà des ulcères gastroduodénaux, cette bactérie serait également responsable de 90 % des gastrites chroniques.
Par ailleurs, Helicobacter pylori figure dans le groupe des agents cancérogènes de catégorie I (cancérogénicité certaine chez l’Homme). La présence de cette bactérie est donc un facteur de risque pour le développement de différentes maladies plus ou moins graves. C’est pourquoi, la question se pose de la pertinence d’un dépistage systématique et d’un traitement préventif de toutes les personnes infectées. Il est donc possible que dans quelques années, à l’image de ce qui se fait actuellement en présence d’un ulcère, l’éradication d’Helicobacter pylori soit une indication courante pour de nombreuses pathologies gastriques, que ce soit dans un cadre curatif ou préventif.